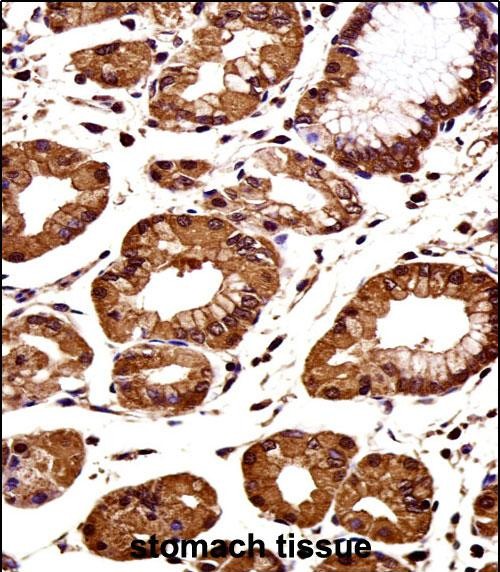

别名:Catenin beta-1, Beta-catenin, CTNNB1, CTNNB应用:WB,IHC,ICC,FCM
反应种属:Human
规格:50μl/100μl
| Description |
|---|
| The protein encoded by this gene is part of a complex of proteins that constitute adherens junctions (AJs). AJs are necessary for the creation and maintenance of epithelial cell layers by regulating cell growth and adhesion between cells. The encoded protein also anchors the actin cytoskeleton and may be responsible for transmitting the contact inhibition signal that causes cells to stop dividing once the epithelial sheet is complete. Finally, this protein binds to the product of the APC gene, which is mutated in adenomatous polyposis of the colon. Mutations in this gene are a cause of colorectal cancer (CRC), pilomatrixoma (PTR), medulloblastoma (MDB), and ovarian cancer. Three transcript variants encoding the same protein have been found for this gene. |
| Specification | |
|---|---|
| Aliases | Catenin beta-1, Beta-catenin, CTNNB1, CTNNB |
| Entrez GeneID | 1499 |
| Swissprot | P35222 |
| WB Predicted band size | 85.5kDa |
| Host/Isotype | Rabbit IgG |
| Storage | Store at 4°C short term. Aliquot and store at -20°C long term. Avoid freeze/thaw cycles. |
| Species Reactivity | Human |
| Immunogen | This CTNNB1 antibody is generated from rabbits immunized with a KLH conjugated synthetic peptide between 692-721 amino acids from the C-terminal region of human CTNNB1. |
| Formulation | Purified polyclonal antibody supplied in PBS with 0.05% sodium azide. This antibody is purified through a protein A column, followed by peptide affinity purification. |
| Application | |
|---|---|
| WB | 1/2000 |
| IHC | 1/100-1/500 |
| ICC | 1/50 |
| FCM | 1/50 |
 |
CTNNB1 Antibody (C-term) (Cat. #P32453) western blot analysis in 293,T47D cell line lysates (35ug/lane).This demonstrates the CTNNB1 antibody detected the CTNNB1 protein (arrow). |
 |
Confocal immunofluorescent analysis of CTNNB1 Antibody (C-term) with 293 cell followed by Alexa Fluor 488-conjugated goat anti-rabbit lgG (green). Actin filaments have been labeled with Alexa Fluor 555 phalloidin (red). DAPI was used to stain the cell nuclear (blue). |
 |
Confocal immunofluorescent analysis of CTNNB1 Antibody (C-term) with T47D cell followed by Alexa Fluor 488-conjugated goat anti-rabbit lgG (green). Actin filaments have been labeled with Alexa Fluor 555 phalloidin (red). DAPI was used to stain the cell nuclear (blue). |
 |
CTNNB1 Antibody (C-term) flow cytometric analysis of 293 cells (right histogram) compared to a negative control cell (left histogram).Alexa Fluor 488-conjugated donkey anti-rabbit lgG secondary antibodies were used for the analysis. |
 |
CTNNB1 Antibody (C-term) immunohistochemistry analysis in formalin fixed and paraffin embedded human colon carcinoma followed by peroxidase conjugation of the secondary antibody and DAB staining.This data demonstrates the use of CTNNB1 Antibody (C-term) for immunohistochemistry. Clinical relevance has not been evaluated. |
|
CTNNB1 Antibody (C-term) immunohistochemistry analysis in formalin fixed and paraffin embedded human stomach tissue followed by peroxidase conjugation of the secondary antibody and DAB staining.This data demonstrates the use of CTNNB1 Antibody (C-term) for immunohistochemistry. Clinical relevance has not been evaluated. |
本公司的所有产品仅用于科学研究或者工业应用等非医疗目的,不可用于人类或动物的临床诊断或治疗,非药用,非食用。
暂无评论
本公司的所有产品仅用于科学研究或者工业应用等非医疗目的,不可用于人类或动物的临床诊断或治疗,非药用,非食用。
 中文
中文 








发表回复